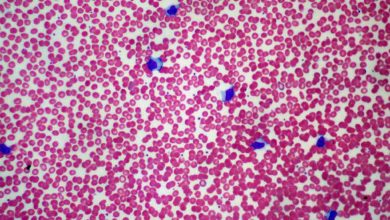

- Le don de sang
- TABAC ET PROBLÈMES BUCCO-DENTAIRES
- VITAMINES « C’est quoi ? »
- POINT DE CÔTE « Douleur au côté »
- BRÛLURES « Des gestes qui soulagent »
- ONYCHOPHAGIE
- AMANDES
- J’AI ENTENDU PARLER DU STÉRILET, C’EST QUOI ?
- QUELS SONT LES BIENFAITS ET LES DANGERS DE LA CONSOMMATION DU CAFÉ ?
- QUELS MOYENS POUR BLANCHIR SAINEMENT MES DENTS ?
Récemment Ajoutés
-
Maladies
MONONUCLEOSE INFECTIEUSE « Maladie du baiser »
La mononucléose infectieuse (MNI) est causée par un virus de la famille des herpès virus (Epstein-Barr Virus) ...
Lire la suite » -
Maladies

RUBEOLE
La rubéole, c’est quoi ? C’est une infection virale immunisante mais très contagieuse ; C’est une maladie bénigne, cependant lorsqu’elle…
Lire la suite » -
Maladies

ENTORSE
L’entorse est une lésion traumatique d’une articulation, responsable d’un étirement ou d’une rupture des ligaments ...
Lire la suite » -
Maladies

CANDIDOSE BUCCALE « Mycose Buccale »
C’est une infection très fréquente, souvent provoquée par un champignon appelé candida albicans ...
Lire la suite » -
Maladies

AUTISME
C’est un trouble qui peut apparaitre chez l’enfant avant l’âge de 3 ans. Il a différentes origines, notamment génétiques ...
Lire la suite »
les plus consultés
-
Sécurité

INTOXICATION A L’HUILE DE CADE «Katrane»
Qu’est-ce que l’huile de cade ? L’huile de cade est une huile extraite de l’arbre…
Lire la suite » -

-

-

-

les plus commentés
-
Mode de vie sain

VACCINATION
La vaccination est une mesure préventive consistant à introduire un agent externe (le vaccin) dans l’organisme par injection ou par voie orale...
Lire la suite » -
Mode de vie sain

L’orthodontie
C’est quoi l’orthodontie ? L’orthodontie est une spécialité dentaire qui vise à corriger les mauvaises postures des mâchoires et des…
Lire la suite » -
Santé mentale

QU’EST-CE QUE LA TOXICOMANIE ?
La toxicomanie est une conduite caractérisée par le besoin impérieux, répétitif de consommer une ou plusieurs drogues à la fois…
Lire la suite » -
Maladies

C’EST QUOI L’OXYUROSE ?
L'oxyurose est due à la présence dans l'intestin d’un parasite « Enterobius vermicularis » ...
Lire la suite » -
Mode de vie sain

BAINS DE SOLEIL : CONSEILS UTILES
Les gens aiment prendre des bains de soleil. Ses rayons sont bénéfiques pour la santé. Cependant, il faut que tu…
Lire la suite »
